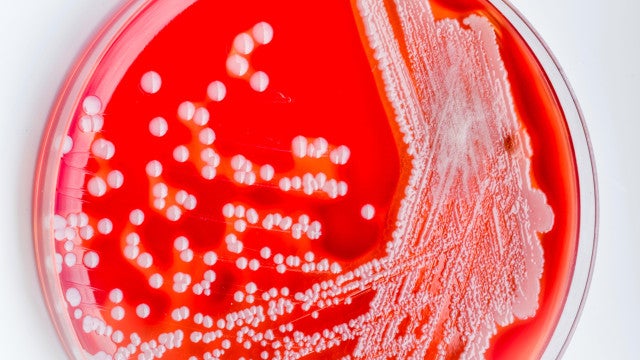
Bactéria "devoradora de carne" preocupa Japão: casos atingem recorde

Bactéria "devoradora de carne" preocupa Japão: casos atingem recorde
Japão enfrenta um surto preocupante de síndrome do choque tóxico estreptocócico (STSS), uma infecção bacteriana rara e potencialmente fatal. Segundo dados oficiais, o número de casos atingiu níveis recordes, causando apreensão nas autoridades de saúde.
Até o dia 2 de junho, o Ministério da Saúde do Japão contabilizou 977 casos de STSS, com 77 mortes registradas entre janeiro e março deste ano. Esse número já supera o recorde do ano passado, e representa o maior número de infecções por essa bactéria desde 1999.
Sintomas e riscos da STSS:
A STSS é causada pela bactéria streptococcus A, que geralmente provoca apenas febre e infecções de garganta em crianças. No entanto, em casos raros, a bactéria se torna invasiva, produzindo uma toxina que se espalha pela corrente sanguínea e leva a complicações graves.
Os sintomas da STSS incluem:
Febre alta
Dores musculares intensas
Vômitos
Diarreia
Erupções cutâneas
Em casos graves: pressão arterial baixa, inchaço e falência múltipla de órgãos
Fatores por trás do aumento ainda são um mistério:
As autoridades de saúde ainda investigam as causas do aumento repentino de casos de STSS no Japão. Algumas hipóteses sugerem que o enfraquecimento do sistema imunológico devido à pandemia de Covid-19 possa estar contribuindo para a proliferação da bactéria.
Leia Também: Exército de Israel diz ter exterminado cerca de metade das forças do Hamas em Rafah
Notícias ao Minuto Brasil – Mundo
Read More



